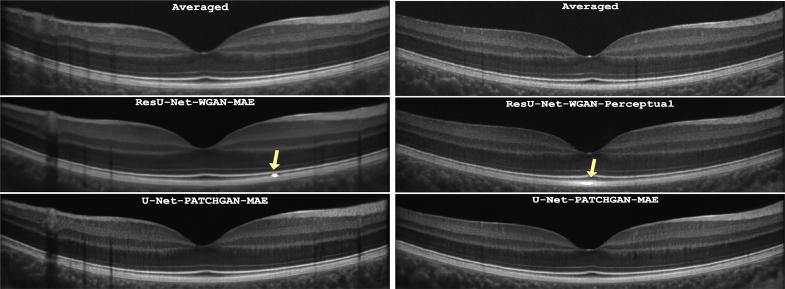

利用生成对抗网络采用纹理损失对光学相干断层扫描(OCT)图像进行去噪。
Employing texture loss to denoise OCT images using generative adversarial networks.
作者信息
Mehdizadeh Maryam, Saha Sajib, Alonso-Caneiro David, Kugelman Jason, MacNish Cara, Chen Fred
机构信息
The Australian e-Health Research Centre (AEHRC), CSIRO, WA, Australia.
School of Physics, Mathematics and Computing, University of Western Australia (UWA), WA, Australia.
出版信息
Biomed Opt Express. 2024 Mar 11;15(4):2262-2280. doi: 10.1364/BOE.503868. eCollection 2024 Apr 1.
OCT is a widely used clinical ophthalmic imaging technique, but the presence of speckle noise can obscure important pathological features and hinder accurate segmentation. This paper presents a novel method for denoising optical coherence tomography (OCT) images using a combination of texture loss and generative adversarial networks (GANs). Previous approaches have integrated deep learning techniques, starting with denoising Convolutional Neural Networks (CNNs) that employed pixel-wise losses. While effective in reducing noise, these methods often introduced a blurring effect in the denoised OCT images. To address this, perceptual losses were introduced, improving denoising performance and overall image quality. Building on these advancements, our research focuses on designing an image reconstruction GAN that generates OCT images with textural similarity to the gold standard, the averaged OCT image. We utilize the PatchGAN discriminator approach as a texture loss to enhance the quality of the reconstructed OCT images. We also compare the performance of UNet and ResNet as generators in the conditional GAN (cGAN) setting, as well as compare PatchGAN with the Wasserstein GAN. Using real clinical foveal-centered OCT retinal scans of children with normal vision, our experiments demonstrate that the combination of PatchGAN and UNet achieves superior performance (PSNR = 32.50) compared to recently proposed methods such as SiameseGAN (PSNR = 31.02). Qualitative experiments involving six masked clinical ophthalmologists also favor the reconstructed OCT images with PatchGAN texture loss. In summary, this paper introduces a novel method for denoising OCT images by incorporating texture loss within a GAN framework. The proposed approach outperforms existing methods and is well-received by clinical experts, offering promising advancements in OCT image reconstruction and facilitating accurate clinical interpretation.
光学相干断层扫描(OCT)是一种广泛应用的临床眼科成像技术,但散斑噪声的存在会掩盖重要的病理特征并阻碍准确分割。本文提出了一种结合纹理损失和生成对抗网络(GAN)对光学相干断层扫描(OCT)图像进行去噪的新方法。以前的方法已经集成了深度学习技术,从采用逐像素损失的去噪卷积神经网络(CNN)开始。虽然这些方法在降低噪声方面有效,但它们经常在去噪后的OCT图像中引入模糊效果。为了解决这个问题,引入了感知损失,提高了去噪性能和整体图像质量。基于这些进展,我们的研究重点是设计一种图像重建GAN,它能生成与金标准(平均OCT图像)具有纹理相似性的OCT图像。我们利用PatchGAN判别器方法作为纹理损失来提高重建的OCT图像的质量。我们还比较了UNet和ResNet作为条件GAN(cGAN)设置中的生成器的性能,以及将PatchGAN与瓦瑟斯坦GAN进行比较。使用正常视力儿童的真实临床以黄斑为中心的OCT视网膜扫描,我们的实验表明,与最近提出的方法如暹罗GAN(PSNR = 31.02)相比,PatchGAN和UNet的组合实现了卓越的性能(PSNR = 32.50)。涉及六名蒙面临床眼科医生的定性实验也更倾向于具有PatchGAN纹理损失的重建OCT图像。总之,本文介绍了一种通过在GAN框架内纳入纹理损失对OCT图像进行去噪的新方法。所提出的方法优于现有方法,并受到临床专家的好评,在OCT图像重建方面提供了有前景的进展,并有助于准确的临床解读。